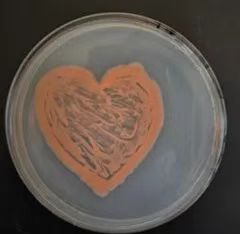
aafeadde2e681d679fc3cf89c70c131.jpg
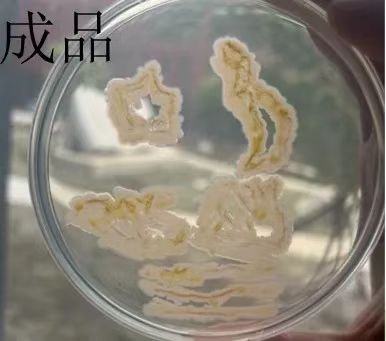
a3fcf8be33a8ba4cbedfeb940e908bc.jpg

近日,我校医学技术学院在2号楼A303成功举行微生物培养皿接种艺术大赛,赛事旨在通过微生物培养皿创作艺术图案,融合科学与艺术,激发学生创新思维,展现微生物培养的独特美感。大赛评委由学院院长李明成教授及医学检验技术专业教研室教师组成。


微生物培养皿接种艺术大赛决赛环节活动现场
参赛报名团队20组,经过半个月的创作,有10组团队进入赛事决赛环节,选手们通过PPT进行展示与演讲,他们以微生物为“颜料”,培养皿为“画布”,充分发挥自己的想象力和创造力,将原本肉眼难以察觉的微生物转化为一幅幅精美的艺术作品。

作品名称《杂交水稻之父》

作品名称《彩蝶翩翩》
作品名称《医心》

作品名称《蝶影星光》

作品名称《蝴蝶》
作品名称《中秋明月》
经过各团队全方面的展示汇报,评委们从作品的创意性、科学性、艺术表现力以及微生物培养的技术难度等多个维度进行综合评审。作品《杂交水稻之父》(创作者:张旭、屈琪、温暖)荣获本次大赛的一等奖,该作品以微生物勾勒出的杂交水稻之父袁隆平,展现伟人的风貌。作品《彩蝶翩翩》(创作者:范东月、徐丽)和《医心》(创作者:安芳、卢昊宇)荣获本次大赛的二等奖,《彩蝶翩翩》利用微生物再现了梁祝神话故事,探寻了蝴蝶背后深邃的精神密码;《医心》以医者仁心为灵感,传递了对医者仁心的崇高赞美与致敬。此外,三等奖获奖项目为4项。

一等奖获得者:2023级医学检验技术专业三班屈琪(左)、2023级医学检验技术专业三班张旭(右)

二等奖获得者:2023级医学检验技术专业四班徐丽(左一)、2023级医学检验技术专业四班范东月(左二)、2023级医学检验技术专业六班安芳(右二)、2023级医学检验技术专业六班卢昊宇(右一)

三等奖获得者:2023级医学检验技术专业三班张熙(左)、2023级医学检验技术专业四班徐丽(中)、2023级医学检验技术专业三班方宏(右)

三等奖获得者:2023级医学检验技术专业四班刘岩(左)、2023级医学检验技术专业四班金家国(右)
此次微生物培养皿艺术设计大赛的成功举办,为医学检验技术专业学子搭建了一个创新实践与才华展示的立体舞台。通过科学与美学的跨界碰撞,不仅拓宽了学科认知维度,而且开辟了微生物科普传播的新路径。未来,医学技术学院将持续深化“以赛促学、以赛促教”的育人理念,通过构建更多元化的实践教学体系,持续激发学生在专业领域的创新潜能。
文案撰写:李明娜
排版编辑:郑羽
出品:大学生融媒体中心
初审:刘子渤
复审:李明成
终审:毕成国